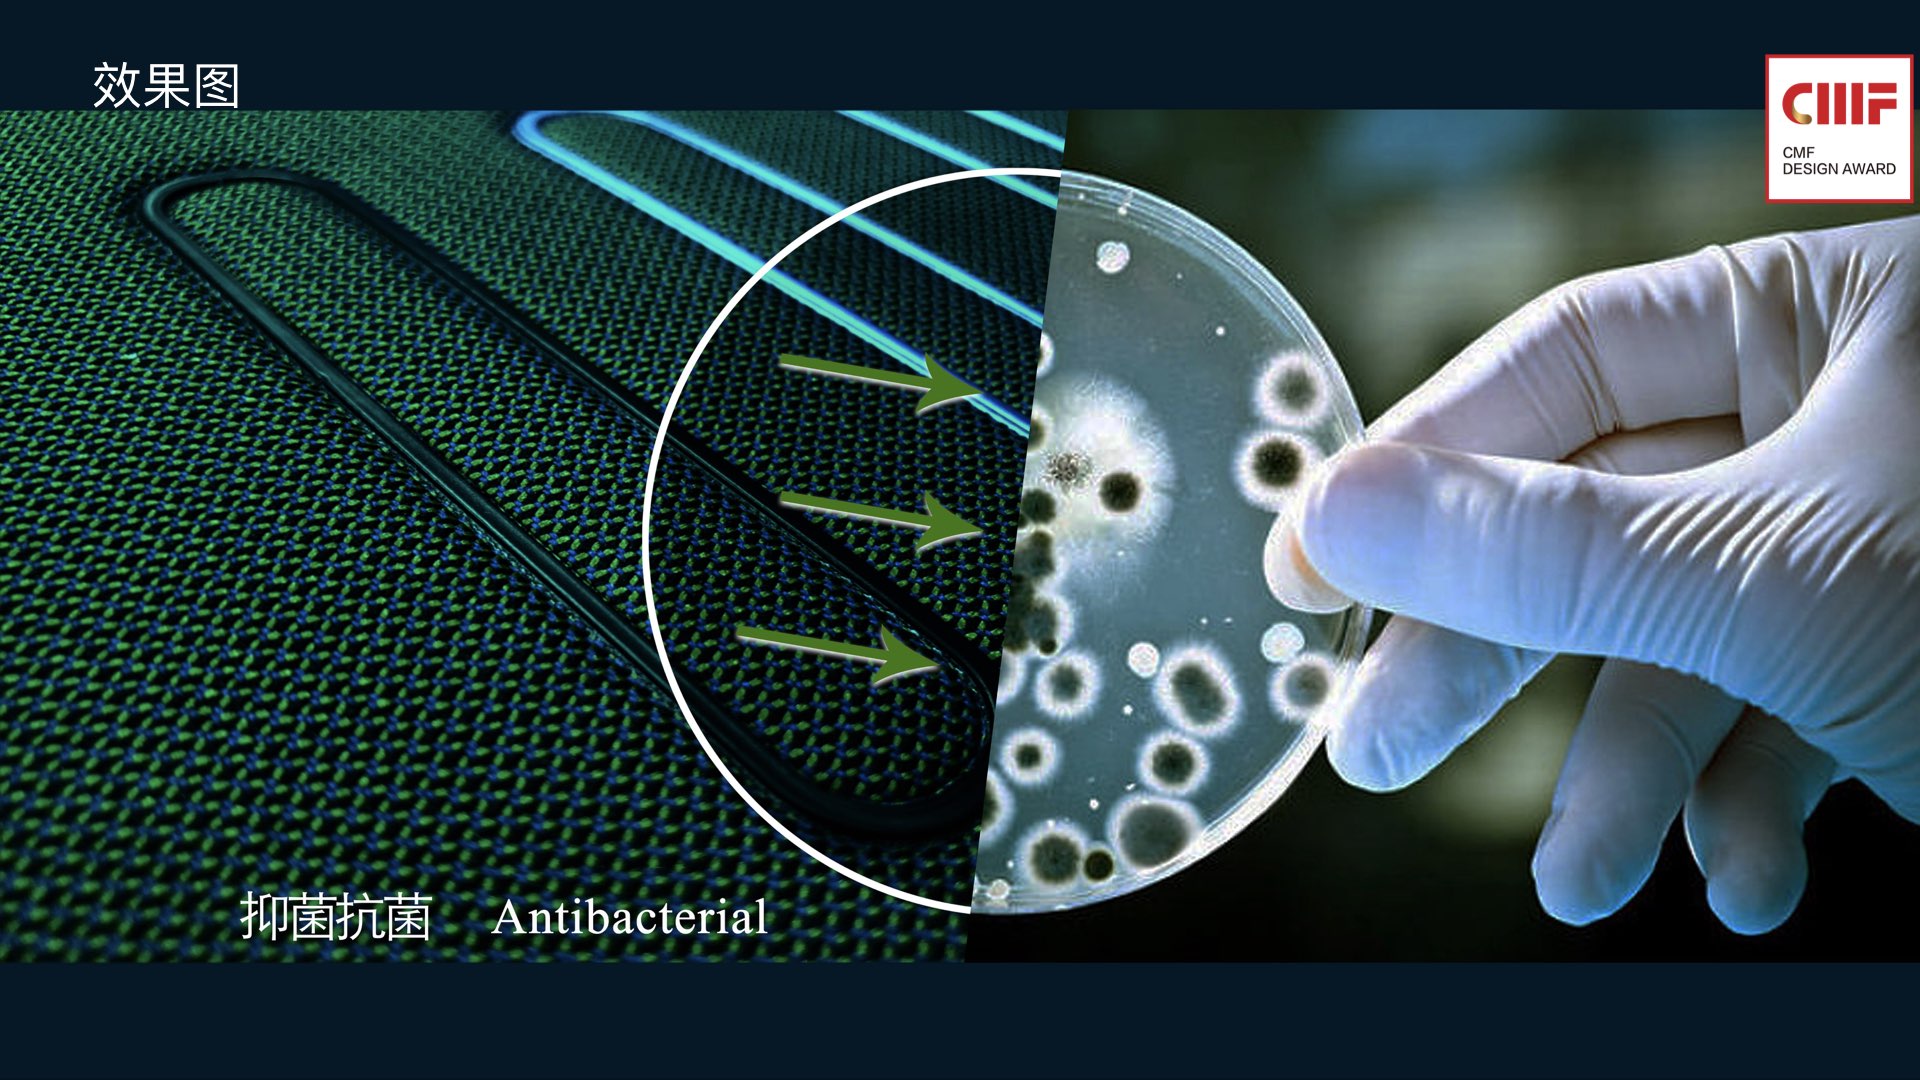
CMF design，cmf，CMF Design Award，2019 international CMF Design Award，

【2018·材料创新奖】【2018·网络人气至尊奖】旷达科技-生态多功能车用内饰面料
2019-08-14
Other Industries
932
5
关注
私信
 China · Home Appliance
China · Home Appliance
【2018·材料创新奖】【2018·网络人气至尊奖】旷达科技-生态多功能车用内饰面料
2019-08-14
Other Industries
932
5
关注
私信
 China · Home Appliance
China · Home Appliance
China · Home Appliance
关注
私信
点赞
收藏
返回顶部

留言板 (0)
评论为空